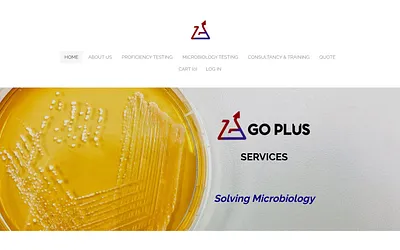
www.goplusservices.com snapshot

www.goplusservices.com
GO PLUS SERVICES - Solving Microbiology
Go Plus Services provides affordable and cost-effective microbiological proficiency testing programs and microbiological testing services along with microbiology training courses and consultancy.
Last seen: January 17th at 10:45am — Visit site